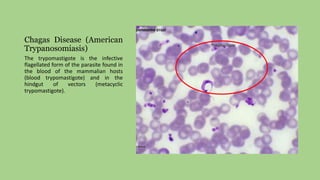
Chagas Disease (American
Trypanosomiasis)
The trypomastigote is the infective
flagellated form of the parasite found in
the blood of the mammalian hosts
(blood trypomastigote) and in the
hindgut of vectors (metacyclic
trypomastigote).

The document discusses Chagas disease, also known as American trypanosomiasis. It is caused by the protozoan parasite Trypanosoma cruzi. The disease was first described in 1909 by Brazilian physician Carlos Chagas. Chagas discovered the organism and infection in humans. The disease affects an estimated 8 million people worldwide and is emerging as an issue in the United States through immigration. Transmission occurs through contact with infected triatomine bugs or blood transfusions. There is no vaccine and treatment is only partially effective in the acute phase of infection.